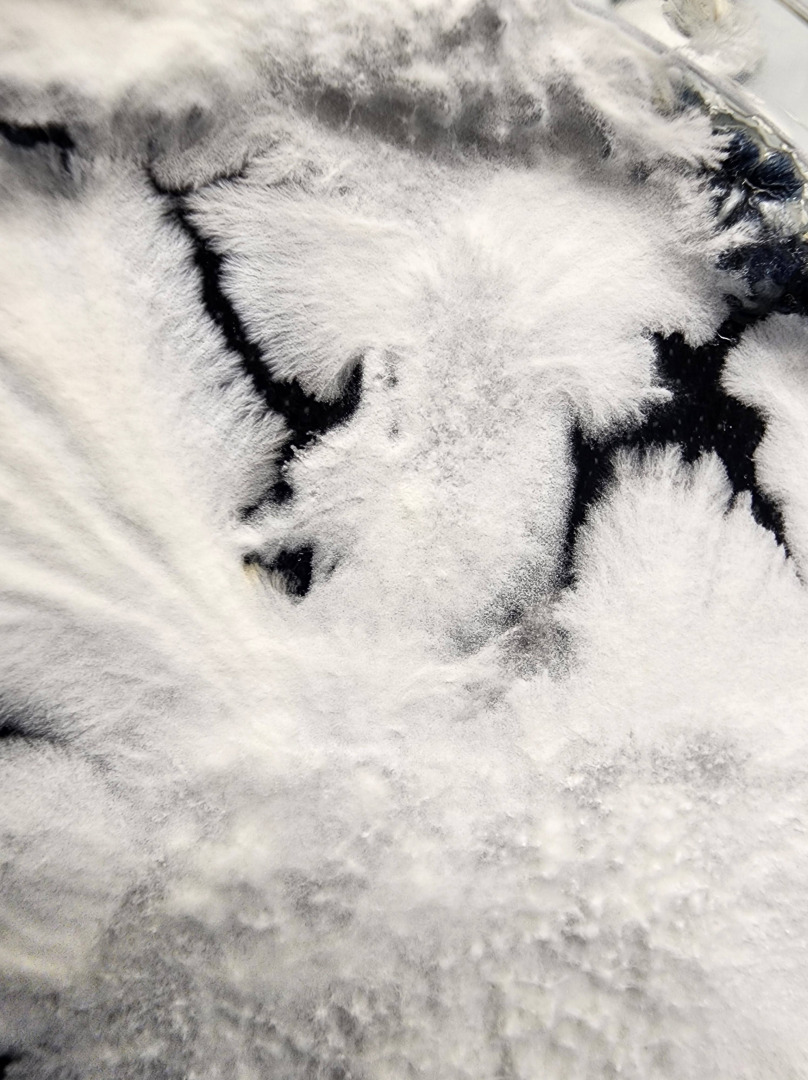

Meet Mya Love Griesbaum | Materials Researcher and Founder of Mycorrhiza Fashion


We had the good fortune of connecting with Mya Love Griesbaum and we’ve shared our conversation below.
Hi Mya Love, what’s the most important lesson your business/career has taught you?
Transformative thinking doesn’t happen in isolation; it thrives at the intersection of disciplines. To grow a company into something you’re truly proud of, you have to step outside your bubble and talk to people you wouldn’t normally cross paths with, people from entirely different fields and perspectives.
Mycorrhiza Fashion was sparked by a materials scientist (me!) searching for a climate-positive solution. However, it only evolved into something impactful because I was willing to admit how much I didn’t know. By building a team that spanned from chemical engineers to fashion designers, we were able to craft a product that’s not only sustainable, but relevant to how people live and dress.
The most powerful ideas come when you make space for others at the table and listen.
What should our readers know about your business?
Mycorrhiza Fashion is a textile company creating sustainable, fungi-based fabrics from the waste produced by fast fashion. We don’t just aim to reduce harm; we actively reverse it. By using mycoremediation and circular design, our materials are engineered to help heal the environment, not just do “less damage.” That distinction matters. We’re not here to greenwash or slap on a label. We’re here to reimagine what fashion can be when rooted in responsibility and regeneration.
What I’m most proud of is staying true to our mission: building a completely sustainable material, from sourcing to end-of-life. That’s rare in this space. We’ve grown not by cutting corners, but by leaning into our values, especially when it’s hard.
Getting to this point has meant asking for help often and listening deeply. I’ve learned to let my values guide me through every challenge. When building the team, one non-negotiable was surrounding myself with people who not only had strong technical skills but also shared a deep sense of empathy and integrity.
One of the biggest lessons? Learn how to genuinely connect with others! I don’t love the word “networking.” It feels transactional. Success in business comes from sincere connections: asking questions, listening to people’s stories, finding shared purpose, and offering support. That’s how strong, lasting relationships (and impactful collaborations) are built.
What I want the world to know is that we’re not just creating new materials; we’re engineering based on nature’s blueprints. Sustainability shouldn’t feel like a step backward to cavemen times. We’re here to show that the next stage for our planet is the coevolution between humans, nature, and technology. At Mycorrhiza Fashion, we draw inspiration from the symbiotic mycorrhizal networks that connect and sustain entire ecosystems, just as we aim to create materials and systems that foster harmony between people and the planet.
This fight against the climate crisis isn’t a lost cause; it’s an open invitation. You just have to say yes!

Any places to eat or things to do that you can share with our readers? If they have a friend visiting town, what are some spots they could take them to?
Daytime Adventures
Little Five Points: Start with thrifting at Rag-O-Rama. It’s the perfect blend of funky/vintage finds.
World of Coca-Cola: Go light on lunch because you’ll be sipping soda flavors from all over the world!
Fernbank Museum of Natural History: For dino lovers and nature nerds alike.
Piedmont Park Picnic + Beltline Walk: Pack a picnic and people-watch in Piedmont, then stroll the Beltline. If it’s the weekend, hit up the pop-up markets.
Day Trip Options: Head out to Stone Mountain or Kennesaw Mountain for a little nature fix and some gorgeous views.
_______
Places to Eat
Dinner
Chattahoochee Food Works: So many options for when everyone in the friend group has a taste for something different!! My fav is the bao and soft serve from Mushi Ni
Kamayan ATL: Incredible Filipino food that my friends and I always crave
La Semilla: Plant-based Latin food. Super cute for date nights!
Desta Ethiopian Kitchen: Generous portions and hearty veggie options
Anh’s Kitchen (Midtown): The go-to for late-night pho (open till 2 AM!)
Dessert
Big Softie: Classic soft serve
The Creamy Spot: Plant-based soft serve!
Cinnaholic: Gourmet cinnamon buns (instant serotonin!!)
Eighty7Sweets: Once got a discount for being a woman in STEM
___
Nightlife
MSR: My favorite LGBTQ+ bar in the city. Good vibes, a welcoming crowd, and free karaoke on Wednesdays!
For what’s trending or happening that week, I always check out @where2atlanta and @atlanta.bucketlist on Instagram!

Who else deserves some credit and recognition?
I owe so much to the core team who’ve been in the trenches with me, whether in the lab, in the field, or out interviewing and ideating: Ben Collins, Eric Samelo, Nancy McNichols, Julia Fleischman, and Chee Hao Teo. Their dedication has shaped every step of this journey.
I’m also deeply grateful to my mentors from CREATE-X, SUSTAIN-X (especially Andre Calmon, Kjersti Lukens, and Jackie Stenson), and the Georgia Tech MSE department, who have guided me with wisdom, honesty, and fierce encouragement.
And a special shoutout to Alison Onstine for being a rock in the lab!
Wouldn’t be here without them!
Website: https://www.mycorrhizafashion.com/
Linkedin: https://www.linkedin.com/in/myalovegriesbaum/




Image Credits
Princess Empel, Chelsea Yang, Liz Kelly
